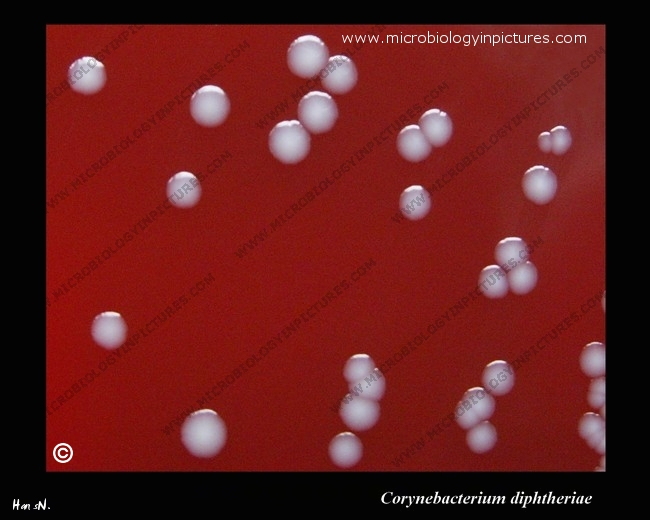

Corynebacterium diphtheriae biotype gravis cultivated on Columbia agar with 5% defibrinated sheep blood. Biotype mitis and gravis produce larger, convex colonies with weak beta-hemolysis. Cultivation 24 hours, 37 °C in an aerobic atmosphere enriched with 5% carbon dioxide.